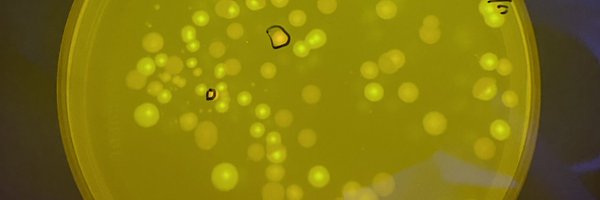
EvoGibbs Profile Banner

Evan Gibbs
@EvoGibbs
Followers
305
Following
2K
Media
30
Statuses
483
PhD Candidate, Bacterial Regulation & Transport Lab @BRaTlab
Awabakal Lands
Joined July 2020
Great work @ClaudesLee what an achievement
@YeastZoo legend @ClaudesLee presents on novel wild yeasts of the zoo at the @Uni_Newcastle with support from the @ARC_CoESB #synbio
0
0
3
Calling all citizen scientists, we have news! The Great Australian Wildlife Search has launched. This exciting program between Odonata Foundation, EnviroDNA and the @MD_Basin_Auth is using innovative eDNA techniques to identify and map species across Australia.
1
6
22
A fresh take and really brilliant review by @BRaTlab @mbiojournal
Check out this update on our understanding of the Gram-negative cell envelope permeability barrier. #mBio
1
2
5
Can’t wait to chat about all things yeast!
The Wild Yeast Zoo team are heading to @Woodfordia for the Folk Festival! Big shout out to the @ARC_CoESB and @inspiringaus through @InspiringNsw and @InspiringQld for their support and write-up below https://t.co/Ed5hzIJtoq
0
0
4
We're hiring an Analytical Chemist ( https://t.co/7FuHiCudpH) and 2x Bioprocess Engineers ( https://t.co/p5gbxAFpD0)
@BioNumber8! Come and join our incredible team in Sydney to help decarbonise Agriculture and build a sustainable bio-economy.
number8.bio
Number 8 Bio is a scientist-led start-up in Sydney that makes scalable and affordable enteric methane mitigation feed additives for livestock. We have a unique approach to managing rumen energy flows...
1
18
23
Attending #ASM2023 @AUSSOCMIC today? #Day2 Pop by my poster #210 tonight on #ColdPlasma #PlasmaActivatedWater as a pre-treatment in the context of #Biofilm infected #ChronicWounds 🥹 Let’s call this the soft launch for my upcoming paper!!!?! 👀📝 *Watch this Space* #S00N
4
12
80
Excited to be #BiofilmBaddie’n on something a little different - @ARC_CoESB BPA $25,000 #EMCR #Grant on #Kombucha with @joachim_steen @EvoGibbs and Gang! Am I Diversifying ?! #SyntheticBiologist #MultiOmics 😎👩🏽🔬🧫🧃✨
Happy to announce that I'm leading a project that just received 25k from @BioplatformsAus to investigate #cellulose production in #microbial communities! @ARC_CoESB @NeilanBGGM @BRaTlab @EvoGibbs @HKNVee @axa_elbiote @Luis_Quijano_1 @TiffMNelson #synbio #kombucha
0
2
5
Happy to announce that I'm leading a project that just received 25k from @BioplatformsAus to investigate #cellulose production in #microbial communities! @ARC_CoESB @NeilanBGGM @BRaTlab @EvoGibbs @HKNVee @axa_elbiote @Luis_Quijano_1 @TiffMNelson #synbio #kombucha
1
3
23
While they grant a lavish 7% pay rise to the VC's already exorbitant salary, they conveniently ignore the hardworking staff who allow Our University to function. That’s one of the reasons I am striking today! @Uni_Newcastle @NTEUnion
#UONStrike #WeAreUON
Well well well... @Uni_Newcastle management can afford a 7% pay rise to the VC's already exorbitant salary but somehow can't afford to give workers a pay rise for two years Join us at #UONStrike tomorrow to demand fair pay for staff! Full article: https://t.co/2tVE7YeSyk
3
41
93
Soil microbiomes must be explicitly included in One Health policy | Nature Microbiology
nature.com
Nature Microbiology - An integrated science–policy–society interface that explicitly considers soil microbiomes is needed to achieve One Health goals.
2
88
212
Here is the flyer for our survey about #antibiotic use. Could win one of eight $50 shopping vouchers. More information or to take part click the link https://t.co/ENNJIahTAd
Looking for #Australians aged 18 years and older who visited a medical practitioner at least once in the past 2 years for an online survey about #antibiotic use.Could win one of eight $50 shopping vouchers.More information or to take part click the link
2
2
3
A little teaser. From left: blue/white screening with amilCP, SDS-PAGE of expression -/+ cumate, induction of GFP using cumin (plates smell great!) Note cumin=$0.05/g vs. IPTG=$50/g. Results c/o Mark Somerville... he's always finding ways to make synbio more accessible and fun
1
5
27
Our broad host range expression vector pUS250 is now in AddGene: https://t.co/rZQY5baMN5. = Huge MCS, GoldenGate & BioBrick compatible = Blue/white selection without X-gal = Cumate promoter: tight control = Inducer is cheap & non-toxic, and can even be replaced with cumin !
7
25
115
So much fun getting a visit from @UNSWBABS yesterday. Phd student Yibo Wu visited us at @NeilanBGGM to learn how to transform #cyanobacteria! The next couple of weeks, we'll cross our fingers 😅😁 @Uni_Newcastle @UON_research @UNSW #phdlife #science #collaboration
0
2
12
Yesterday, we had our very first AGM followed by a true Aussie BBQ! Welcome the very first synthetic biology club at @Uni_Newcastle (even though, we've been around fo a bit)! And just in time for registration deadlines for both @iGEM and @SynBioChallenge! Stay tuned for more!
2
5
18
@ATinyGreenCell dairy foods (and meat) are high in tryptophan; many microbes can convert this to tryptamine or indole, which can then be oxidised and dimerised to indigo and related pigments. this is why magic shrooms stain blue. maybe its both blue *and* magic soup...
chemistryworld.com
Chemists reveal colourful indigo-like polymers that turn psychotropic mushrooms blue when cut
0
5
14
CALL FOR NOMINATIONS! 🦠 Dm us your selections for the following roles before 5PM 14/4: President/Chairperson Treasurer Secretary See you at the meeting and social barbecue on 18/4!!
0
2
3
It’s time for our 2023 AGM! We will making important decisions about the club and its future directions. Afterwards, at 12, will be a social BBQ where everyone is welcome to have a chat and suggest any ideas you want to do in the future! <3
0
2
3